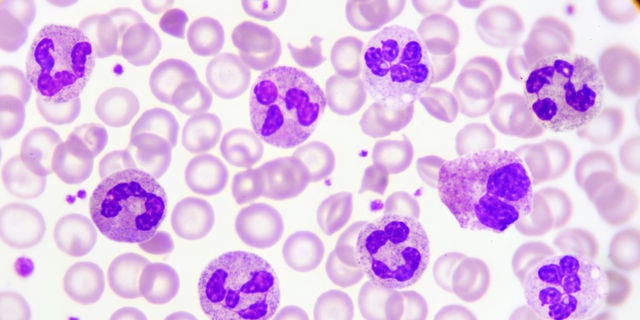

小林麻央さん 白血球改善にトランポリン挑戦!白血球と健康の関係とは?
2017年3月23日(木)に更新された
乳がんで闘病中のフリーアナウンサー小林麻央さんのブログで、海老蔵さんからのアドバイスにより、白血球を上げるためにトランポリンに挑戦されたことが語られておりました。 (
参考)
一体、トランポリンと白血球はどのような関係があるのでしょうか?また、白血球の数によって私たちの健康にはどのような影響があるのでしょうか?
今回は白血球の基本的な免疫の仕組み、免疫機能を上げる方法なども含め、医師に詳しく解説していただきました。
トランポリンで白血球の数値は上がる?

トランポリンで運動することで、
糖尿病患者のインスリン抵抗性・
脂質代謝異常・
肥満が改善したという論文がありますが、「トランポリンをすることで白血球の機能や数が改善した」という直接的な論文は明らかになっていません。
しかしながら、トランポリンは有酸素運動であり、適度な有酸素運動はNK細胞(ナチュラルキラー細胞)の活性が上昇し、T細胞・単球の細胞数が上昇し、逆に運動強度が強すぎると、かえって免疫活性が低下すると言われています。
適度な運動とは、最大酸素摂取量の50~60%程度の強さで、1日20~60分程度、週3回以上の頻度で長期間継続するのが理想的とされているので、トランポリンでの有酸素運動が、免疫力の向上に有効である可能性は十分あると思われます。
《参照》
運動によるさまざまな免疫変動と意義
白血球の役割と種類

白血球は血液中に含まれる免疫担当細胞で、リンパ球・顆粒球・単球があります。
T細胞、B細胞、NK細胞に分類されます。体内に侵入した病原体や異物を認識し、抗体を作り、攻撃して排除します。
がん細胞はもともと自分の体の一部ですが、自分の細胞とは異なる特徴を持っているため、リンパ球によって攻撃され排除されることもあります。
顆粒球
特殊なインクで染めると、細胞内につぶつぶ(顆粒)があるように見えます。染まりやすいインクが酸性か、塩基性か、中性かによって、好酸球・好塩基球・好中球に分類されます。
つぶつぶに含まれた殺菌剤で病原体を排除したり、アレルギー反応を起こすことに関係します。
単球
病原体や異物粒子を取り込んで消化します。また免疫系の働きを調節したり指令を出したりするためのサイトカインという微量物質を分泌します。
白血球の基準値
白血球全体の数は、3500~9500個/μL程度ですが、年齢や検査施設によって基準値には差があります。 白血球の異常で懸念される疾患

白血球の数は多ければ多いほうが良いというわけではなく、増えすぎている場合は白血病などの病気であることもあります。
白血病では不良品の白血球ばかりが増えるため、数が多くても免疫機能は低下します。白血球数だけが免疫機能を反映するわけではありません。
白血球が少なすぎる場合
■ 白血球が作られていない
骨髄の病気、抗がん剤や放射線治療の影響など
■ 白血球が破壊・消費されてしまう状態
脾臓機能亢進、ウイルス感染症、 HIVウイルス感染によるAIDSなど
白血球が多すぎる場合
白血病、がん、骨髄の病気、 結核感染、自己免疫疾患、 ストレスや 妊娠による増加もあります。赤ちゃんでは大人より白血球が多くなります。 免疫機能を改善する効果的な方法

野菜や果物を食べる
新鮮な野菜や果物を食べると、サイトカインや白血球の働きが改善すると言われています。
適度な運動
運動習慣をもつよう心がけ、具体的には30分以上の運動を週2〜3日以上行うことが良いでしょう。
■ 18〜64歳
歩行又はそれと同等以上の強度の身体活動を毎日60分以上行う。 または、息が弾み汗をかく程度の運動を毎週60分行う。
■ 65歳以上
横になったままや座ったままにならなければどんな動きでもよいので、 身体活動を毎日40分行う。
乳酸菌の摂取
腸は免疫機能の調節に大切な役割をしています。乳酸菌・オリゴ糖・食物繊維を取ることで腸内の善玉菌を増やし腸内環境を整えることは免疫機能の向上に効果的です。
笑う
笑うことにより、興奮が免疫機能をコントロールする間脳に伝わることで、神経伝達物質のNK細胞が作られます。 NK細胞は異物を攻撃する細胞の働きを強める効果があり、健康増進に役立ちます。
また、NK細胞は食物アレルギーや自己免疫疾患などのように、過剰に免疫機能が働いてしまう病態に対しても、うまくバランスをとり、いい影響を与えるほうに作用すると考えられています。
免疫機能を下げてしまうNG習慣

体温が低くなると感染を起こしやすくなったり、免疫機能が低下すると分かっています。
また、ストレスや睡眠不足は免疫機能低下につながるので、ストレス発散や正しい生活習慣も心がけましょう。 今後期待される「がん免疫治療」

がんは細胞内の遺伝子のエラーで生じますが、若い人でも毎日数個のがん細胞ができていると言われています。
できてしまったがん細胞は、自分の持っている自爆プログラムで死ぬこともありますが、免疫により異物とみなされ排除されることもあります。
こういったがんに対する免疫を活性化してがんをやっつけよう、という治療が「がん免疫治療」で、最近話題となっているオプシーボなどの薬は、がん免疫を利用しています。 最後に医師から一言がん免疫治療は、今後もがんの新しい治療法として注目されることと思われます。
小林麻央さんのように、ご自身のできる範囲で運動をして、自分の免疫機能を高めることは非常に良いことですね。
(監修:Doctors Me 医師)